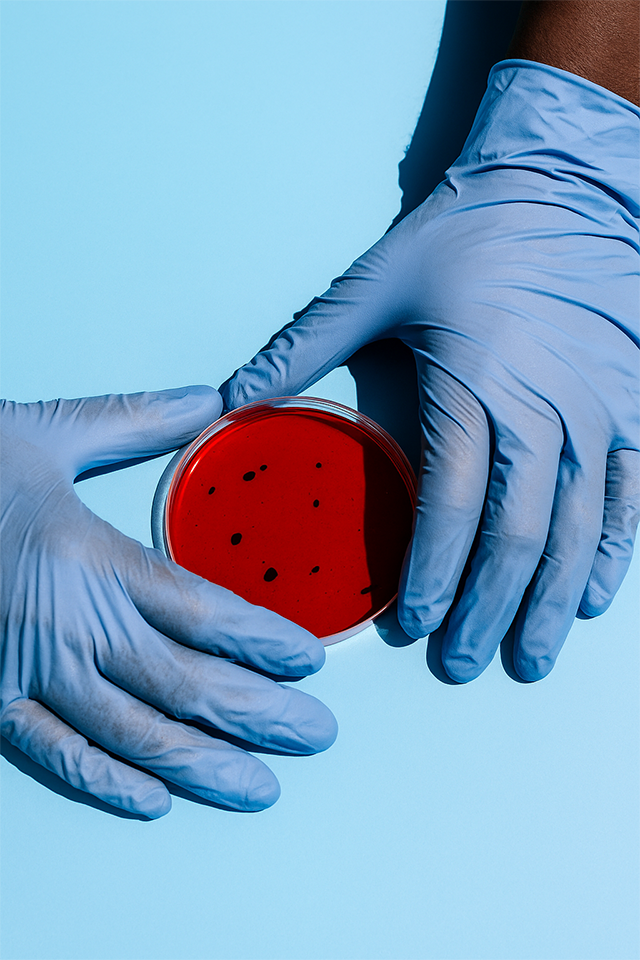

à propos
Laboratoire régional de santé publique, le Laboratoire Rodolphe Mérieux INRB contribue au renforcement de l’accès au diagnostic au plus près des populations locales. Il participe à la surveillance et à la riposte des maladies épidémiques ou à potentiel épidémique, à la recherche translationnelle et la formation du personnel du secteur biomédical et des chercheurs d’autres laboratoires, dans un contexte de ressources limitées. Il est équipé de technologies de pointe qui répondent aux normes internationales les plus exigeantes en matière de qualité, biosécurité et biosûreté.
Technologies de pointe en recherche pour garantir des résultats fiables et qualité optimale.
Le LRM-INRB s’appuie sur des technologies de diagnostic et de recherche de dernière génération pour garantir des résultats précis, rapides et fiables.
Grâce à une infrastructure moderne et une équipe formée aux standards internationaux, nous assurons une réponse efficace aux enjeux de santé publique
d'experience et expertise
Experts qualifiés

Pourquoi nous choisir
Découvrez ce qui fait du LRM-INRB une référence nationale en microbiologie et en diagnostic.
Laboratoire de haute qualité
Chaque analyse est réalisée selon des protocoles validés, avec des équipements de haute précision
Expertise
Une équipe multidisciplinaire composée de chercheurs, biologistes et techniciens formés aux normes internationales.
résultats fiables et précis
Chaque analyse suit des protocoles rigoureux avec des équipements de pointe, garantissant des résultats justes, traçables et reproductibles
personnel hautement qualifié
Nos experts en microbiologie, biologie moléculaire et biosécurité sont formés aux meilleures pratiques internationales et assurent un service de qualité supérieure
S'abonner à notre lettre d'information
Restez en contact avec nous pour recevoir les dernières nouvelles et les offres spéciales.
Addresse
26, Av. Des Orchidées, Q. Les Volcans, Goma
Appel
+243 993 549 796
info@inrbgoma.com | inrbgoma@gmail.com









